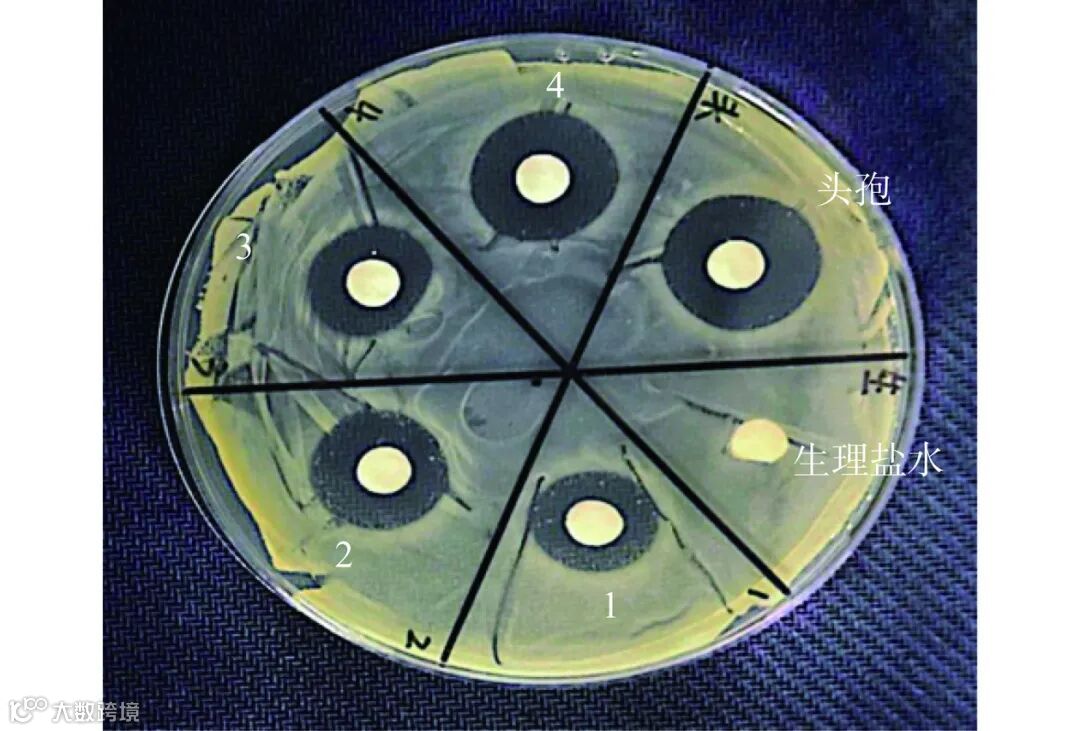

大连海洋大学食品科学与工程学院 的金桥,王涛,曲敏,李伟,佟长青等人采用超声辅助酶解法制备大鲵皮抗菌肽,重点内容如下:1.抗菌肽(AMPs)的特性与重要性:由12-50个氨基酸组成,具有分子量低、广谱抗菌活性、不易产生耐药性等特点。在先天免疫防御中起关键作用,对病毒、细菌和真菌有效。因抗生素耐药性问题严重,抗菌肽成为新型抗菌药物的研究热点。2. 金黄色葡萄球菌的研究意义:因其广泛致病性和耐药性,成为细菌耐药性研究的焦点模型生物。3. 抗菌肽的研究方向与挑战:研究重点包括新抗菌肽的发现、结构特性、作用机制、人工设计、应用可行性等。实际应用面临毒性、稳定性差、生产成本高等问题。4. 大鲵的药用价值与研究背景:大鲵是中国特有的珍贵两栖动物,全身富含生物活性成分。两栖类动物皮肤因长期进化产生大量抗菌活性物质,但大鲵皮肤抗菌肽研究尚未见报道。5. 本研究的目标与方法:以大鲵皮为原料,采用超声辅助酶解法制备抗菌肽。通过响应面试验优化工艺,分离纯化并分析结构特征。研究其对金黄色葡萄球菌的抑菌机制,为开发大鲵资源提供理论依据。6. 研究意义 :发现新型抗菌肽资源,提高大鲵资源利用效率,延伸产业链,提升经济效益。
摘要:为提高大鲵产品附加值及探索绿色高效的抑菌剂,本研究采用超声辅助酶解法制备大鲵皮抗菌肽,通过响应面试验优化提取工艺,大鲵皮抗菌肽经纯化后,利用红外色谱、圆二色谱、时间飞行质谱、液相色谱-串联质谱联用等方法分析其结构特征及抑菌机制。结果表明,大鲵皮抗菌肽的最优提取工艺为:超声时间16.6 min、超声功率120 W、加酶量18000 U/g、酶解时间5.85 h、底物浓度21.3%,验证试验测得大鲵皮抗菌肽得率为1.164%±0.021%;红外光谱、圆二色谱结果表明,大鲵皮抗菌肽二级结构中无规则卷曲、α-螺旋、β-折叠和β-转角占比分别为45.54%±1.59%、22.67%±0.78%、18.42%±1.05%、13.41%±0.6%;质谱分析结果显示,大鲵皮抗菌肽具有低分子量、高比例疏水性氨基酸的特点;细菌呼吸抑制试验结果表明,大鲵皮抗菌肽主要抑制金黄色葡萄球菌糖氧化代谢中的EMP途径;电镜结果显示,大鲵皮抗菌肽可以破坏金黄色葡萄球菌的细胞膜完整性,改变菌体的膜通透性。以上研究结果为大鲵资源的高值化利用及开发安全高效的天然抑菌剂提供了数据参考。
中性蛋白酶酶解产物对金黄色葡萄球菌抑菌效果最佳(抑菌圈直径8.17±0.03 mm),被选为后续实验用酶。超声功率120 W时肽得率最高(0.959%),抑菌圈直径最大(9.33 mm);超声时间20分钟时效果最佳(肽得率1.088%,抑菌圈9.37 mm)。底物浓度25%、加酶量18000 U/g、酶解温度50℃、酶解时间5小时为最优条件,显著提升肽得率及抑菌活性。酶解时间、超声时间、底物浓度三因素交互作用显著,最终优化工艺为:酶解时间6小时、底物浓度21%、超声时间17分钟,实际肽得率达1.164%±0.021%,与预测值(1.174%)接近。纯化后峰1抑菌活性最强(100 mg/mL时抑菌圈17.34±0.28 mm),最小抑菌浓度(MIC)为1.25 mg/mL,活性呈浓度依赖性。红外光谱显示抗菌肽含α-螺旋和β-折叠结构;圆二色谱表明其以无规则卷曲(45.54%)和α-螺旋(22.67%)为主。质谱鉴定出78个肽段,疏水性氨基酸占比超40%的肽段居多,碱性氨基酸(His/Lys/Arg)可能通过静电作用增强膜结合能力。主要通过抑制EMP途径影响金黄色葡萄球菌呼吸代谢(叠加抑制率仅6.19%);扫描电镜显示抗菌肽导致菌体表面形成孔洞或内陷,破坏细胞结构。

Fig.1 Inhibitory effects of different protease hydrolysis products
注:不同字母表示组间差异显著(P<0.05),图 2 同。

图 2 不同超声辅助酶解条件下大鲵皮酶解产物的肽得率及抑菌活性
Fig.2 Yield and inhibitory effects of enzymatic hydrolysis products from giant salamander skin under different ultrasound assisted enzymatic hydrolysis conditions
Table 2 Design and results of Box-Behnken experimental
Table 3 Variance analysis of regression model
Table 4 Reliability analysis of regression model

Fig.3 Interactions among enzymolysis time, ultrasonic time, and substrate concentration

图 4 大鲵皮抗菌肽葡聚糖凝胶 LH20 洗脱曲线
Fig.4 Elution curve of antimicrobial peptide dextran gel LH20
Fig.5 Inhibitory effect of elution peak 1
注:浓度 1 为 25 mg/mL,2 为 50 mg/mL,3 为 75 mg/mL,4 为100 mg/mL,头孢对照为 1 mg/mL。

Fig.6 Infrared spectrum of antimicrobial peptides from giant salamander skin

Fig.7 Circular dichroism spectrum of antimicrobial peptides from giant salamander skin
Table 5 Secondary structure proportion of antimicrobial peptides from giant salamander skin (%)
Fig.8 MALDI-TOF MS spectrum of antimicrobial peptides from giant salamander skin
Table 6 Sequences of antimicrobial peptides from giant salamander skin
表 7 不同抑制剂抑制金黄色葡萄球菌呼吸代谢的结果
Table 7 Effects of different inhibitors on respiratory metabolism of S. aureus


Fig.9 Morphology of S. aureus under scanning electron microscopy
注:a 为对照组;b 为大鲵皮抗菌肽处理的金黄色葡萄球菌。
大鲵养殖规模扩大,但产品单一化问题突出,高效利用资源成为产业发展的关键。通过超声辅助中性蛋白酶酶解大鲵皮,获得抗菌肽,最优提取工艺参数明确(超声时间、功率等),得率达1.164%。结构分析显示抗菌肽以无规则卷曲为主(45.54%),含高比例疏水性氨基酸且分子量低。抑制金黄色葡萄球菌的HMP代谢途径,通过破坏细胞膜完整性(电镜观察到菌体表面孔洞/内陷)。抗菌肽抑菌活性显著,需进一步研究抑菌谱及具体作用机制以推动实际应用。
引用本文:金桥,王涛,曲敏,等. 大鲵皮酶解产物的制备、结构表征及抗菌活性分析[J]. 食品工业科技,2025,46(16):116−125. doi: 10.13386/j.issn1002-0306.2024090229.
Citation:JIN Qiao, WANG Tao, QU Min, et al. Preparation, Structural Characterization and Antimicrobial Activity of Enzymatic Products from the Skin of Giant Salamander (Andrias davidianus)[J]. Science and Technology of Food Industry, 2025, 46(16): 116−125. (in Chinese with English abstract). doi: 10.13386/j.issn1002-0306.2024090229.
基金项目:张家界市产学研结合创新“揭榜挂帅”项目(JBGS202301)。
佟长青,博士,教授,研究生导师,东北林业大学细胞生物学博士毕业。大连海洋大学食品科学与工程学院教授。主要从事水产品贮藏与保鲜、水产品加工与综合利用、发酵机理等方面的研究。在海洋生物凝集素、海洋药源活性物质、水生生物资源利用等领域,特别是针对大鲵、鲟鱼、牡蛎等生物的活性物质制备及应用进行了深入探索,取得了一些有意义的结果。
本文内容由《食品工业科技》官网www.spgykj.com AI自动生成,欢迎点击阅读原文,获取原文进一步深读。
群聊:食品工业科技作者群

我刊正式组建微信作者群,为作者提供更多的学术与论文资讯,如需进群,请联系刘老师(微信:上方二维码,电话:87244117-8062)。
《食品工业科技》具有以上论文在全世界范围内的复制权、发行权、翻译权、汇编权、广播权、表演权、信息网络传播权、转许可权及以上权利的邻接权,且作者已授权期刊同论文著作权保护期。如需转载,可联系《食品工业科技》编辑部010-87244116,或直接在文末撰写转载来源。